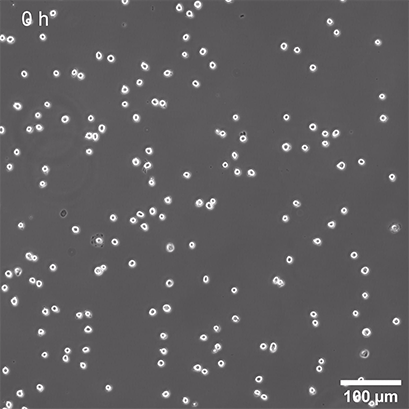
新闻图片10

体外细胞培养是研究细胞功能、了解疾病和发现新药的重要工具。这些实验中的大部分是用在组织培养处理过的塑料容器上以2D单层培养的细胞进行。然而, 活细胞的体内环境看起来完全不同。细胞嵌入由其他细胞和结构成分组成的组织中,称为细胞外基质(ECM;图 1A)。细胞与细胞和细胞与 ECM 的相互作用以及这些组织内的机械力对细胞形态和行为具有至关重要的影响。此外,暴露于营养物、代谢物、氧气和 CO 2活组织或 3D 细胞结构(例如,肿瘤)中的细胞与 2D 单层细胞非常不同(图 1B 和 1C)。
图 1A,活组织中具有细胞间接触和细胞与 ECM 接触的细胞的示意图
图 1B ,3D 肿瘤球体的示意图,外部是增殖细胞,内部是坏死细胞,中间是静止细胞。可以在外部发现高浓度的氧气和营养物,而在内部可以发现高浓度的 CO 2和代谢废物

图 1C,使用ibidi 泵系统灌注培养 14 天后,L929 球体在 µ-Slide 球体灌注、Bioinert中的活/死 FDA/PI 染色,0.75 毫升/分钟
绿色:活细胞(荧光素二乙酸酯,FDA);红色:死细胞(碘化丙锭,PI)。宽场荧光显微镜,10 倍物镜
在建立细胞培养模型以研究细胞功能、特定疾病(例如癌症)或表征某些药物之前,研究人员必须考虑这些因素。为了获得最接近体内的实验结果,尽可能接近地模拟活体组织的生理条件也是有意义的。
在这篇文章中,我们介绍了不同的 3D 细胞培养模型来研究类似体内状态的细胞。
从单层细胞到组织:
虽然细胞仍然主要在经细胞培养处理的塑料表面或涂有蛋白质或厚细胞基质(2.5D 培养)的 2D 单层细胞中培养,但如果您有兴趣在更广泛的环境中培养细胞,则可以从各种 3D 细胞培养模型中进行选择生理方式(图2)。
可以使用基于支架的技术,例如聚合物或水凝胶,它们通过合成化学聚合物或蛋白质网络提供结构支持。或者,可以使用无支架技术获得3D细胞结构,其中可以在没有额外结构支持的情况下形成复杂的细胞聚集体或整个组织。

图 2:2D 和 3D 细胞培养模型概述
在决定哪种技术最适合各自的研究问题时,应考虑这两种方法的优缺点。支架方法考虑了细胞与 ECM 的相互作用,而细胞的环境可以用悬浮生长的球体更好地操纵。为了在显微镜上长期培养和研究 3D 结构,已经开发了特殊的工具和技术,以确保在较长时间内持续提供培养基和模拟生理条件。
基于支架的3D细胞培养模型:
3D 细胞培养模型的支架范围从多孔聚合物膜到模拟 ECM 细胞微环境的复杂水凝胶。
一般来说,水凝胶形成交联聚合物的结构,可以吸收和结合大量的水。在 4°C 或室温下,混合物是液体,但在 37°C 下会形成凝胶。此功能使得可以将液体与细胞混合,然后在 37° 下孵育时将细胞嵌入三维矩阵中。这允许细胞保留特定的体内特征,例如细胞-ECM 相互作用或环境的生理和机械特性。
有不同类型的水凝胶,例如 Matrigel ®或 胶原蛋白,它们来自有机来源。然后,复杂的合成水凝胶具有精确控制其成分(分子、交联剂等)的优势。这允许对各个组件的影响得出不同的结论。
无支架3D细胞培养模型:
独立于支架的方法允许在没有矩阵支持的情况下以 3D 方式培养细胞。它们依赖于细胞自组装成聚集体或球状体的概率。建立了多种技术来促进这种自组装过程。

图 3:在µ-Slide 4 Well中培养的纤维蛋白水凝胶中发芽的人肠成纤维细胞和内皮细胞球体。内皮细胞用 CD31(黄色)染色,成纤维细胞用波形蛋白(红色)染色,DNA 用 DAPI(青色)染色。
共聚焦图像由 H. Nogueira Pinto 拍摄,生物工程 3D 微环境小组,Instituto de Investigação e Inovação em Saúde (i3S),Universidade do Porto,葡萄牙
悬滴技术
悬滴技术是生物学中行之有效的方法,已用于许多不同的应用,例如整个(微生物)生物体的观察或蛋白质的结晶。它利用重力形成从玻璃板上垂下的悬浮液滴。
在过去的十年中,这项技术已经过修改并适用于3D细胞培养应用,允许从细胞悬液中形成球状体而无需支撑支架(图 4)。如今,专门的悬滴板已在市场上销售。然而,虽然这种方法适用于球体的生成,但不可能将其与高分辨率显微镜相结合。

图 4:悬滴法原理
超低吸附(ULA)涂层
所谓的低粘附板涂有中性电荷或亲水性蛋白质或水凝胶,可减少细胞对板表面的附着,从而形成 3D 细胞结构。虽然这种涂层主要防止细胞附着,但在更长的时间后细胞粘附仍然会发生,因为涂层通常只是物理吸附而不是共价结合——因此不是长期稳定的。
生物惰性表面
与标准 ULA 涂层相比,生物惰性表面共价结合并提供稳定的表面钝化。因此,它可以完全防止蛋白质或细胞附着到涂层表面。这促进了细胞间的相互作用和 3D 细胞聚集体的形成,即使在长期实验中也是如此(图 5)。
图 5:ibidi 聚合物盖玻片上生物惰性表面上的球体形成
微图案表面微孔板
在 Bioinert 表面上压印微图案可以使细胞精确粘附在指定位置(图 6)。µ 图案斑点周围的钝化区域有助于形成 3D 细胞聚集体和球状体(图 7 和 8)。

图 6:微图案斑点上细胞附着的动图

图 7:微图案点上球体形成的原理
图 8:接种在 200 µm 粘附点上的 NIH-3T3 细胞系悬浮液,64 小时活细胞成像,相差,4x 物镜
具有特殊几何形状的微孔板、器官芯片微流体和用于长期3D细胞培养的设备
为了体外细胞培养尽可能接近体内条件,器官芯片检测与灌注装置的结合变得越来越重要。对于此应用,细胞被嵌入到微通道中的矩阵中。这些通道可以灌注培养基或药物,用于在流动或药物筛选下进行长期细胞培养(图 9 和 10)。
具有特殊几何形状的微孔板允许进行特定的基于 3D 细胞的测定(例如,伤口愈合或趋化性测定)或模拟不同的器官(例如,肺或肝)。

图 10:L929 成纤维细胞在µ-Slide 球体灌注中显示球体形成,Bioinert,第 1-14 天,接种浓度 5 x 10 5 个 单细胞/ml。
左图:无灌注,每隔一天更换一次培养基。右图:使用 ibidi 泵系统灌注,0.75 毫升/分钟。相差显微镜,10 倍物镜,孔径 800 µm。
总之,通过从 2D 细胞单层转移到 3D 细胞培养,在模拟活组织的生理条件方面取得了巨大进步。这允许更好地读出基于细胞的测定、疾病模型和药物效应,从而使细胞培养总体上更准确,并且是动物模型的更好替代品。